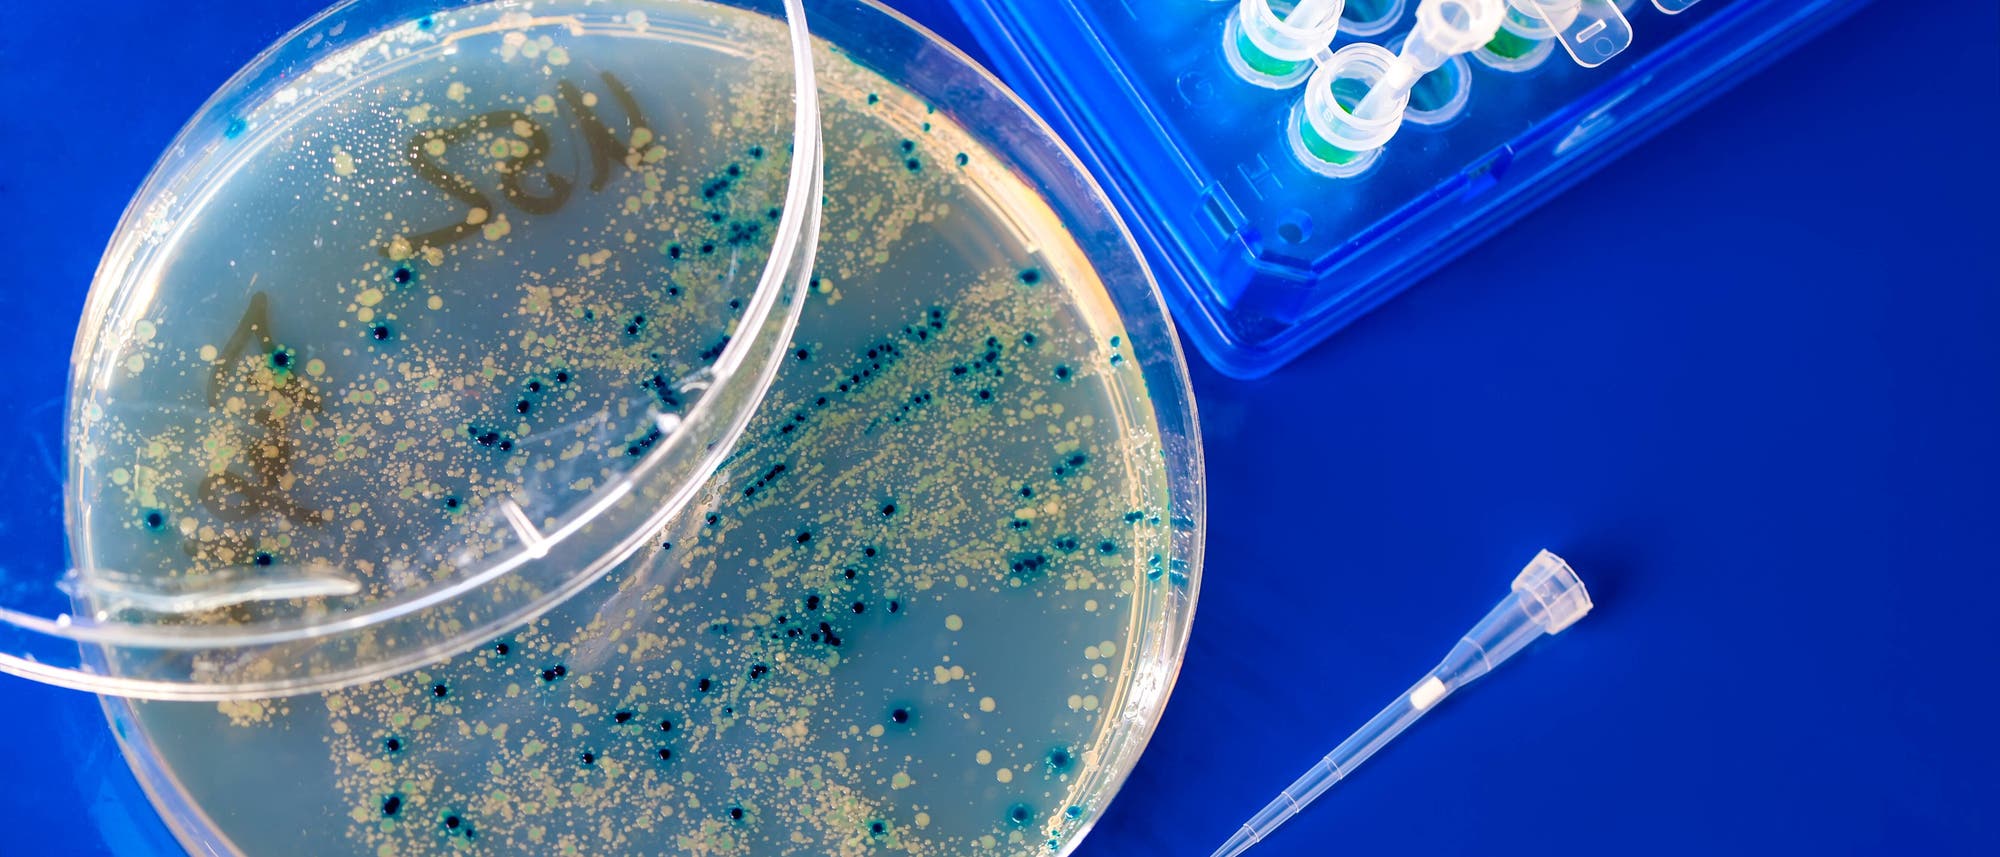
Eine Petrischale mit einer blauen und gelben Bakterienkultur auf einem blauen Hintergrund. Daneben befindet sich eine Pipettenspitze und ein Rack mit mehreren Reagenzgläsern. Die Szene zeigt ein typisches Labor-Setup für mikrobiologische Untersuchungen.

Synthetisches Genom: Forscher lassen KI ein künstliches Virus erzeugen
Ein Forscherteam hat erstmals Viren erzeugt, deren genetischer Bauplan von einer künstlichen Intelligenz (KI) entworfen wurde. Bei den Viren handelte sich um sogenannte Bakteriophagen. Sie waren dank des KI-generierten Erbguts in der Lage, Bakterienstämme von Escherichia coli(E. coli) aufzuspüren und abzutöten.
»Zum ersten Mal haben es KI-Systeme geschafft, vollständige Genomsequenzen zu schreiben«, sagt der Leiter des Teams Brian Hie von der Stanford University. »Der nächste Schritt wäre KI-generiertes Leben.« Dafür bedürfe es allerdings noch erheblicher experimenteller Fortschritte, schränkt sein Institutskollege Samuel King ein.
King ist Erstautor der Studie, die aktuell auf dem Preprint-Server bioRxiv hinterlegt ist. Sie ist noch nicht von Fachkollegen geprüft, lässt aber den Autoren zufolge bereits erkennen, welches Potenzial in der KI steckt. Das Ziel besteht darin, in Zukunft biotechnologische Werkzeuge und neue Therapien hervorzubringen. »Wir hoffen, dass solche Strategien den therapeutischen Einsatz von Bakteriophagen ergänzen und eines Tages auch die Behandlung von Infektionen verbessern können«, sagt Hie.
KI-Modelle haben bisher vor allem DNA-Abschnitte, einzelne Proteine oder teils auch Konstrukte aus mehreren Proteinen erzeugt. Ein komplettes Genom zu entwerfen ist dagegen deutlich schwieriger. Gene wechselwirken stark miteinander und werden durch umfangreiche Regulationsprozesse gesteuert. Dank Fortschritten in der künstlichen Intelligenz könnten die Modelle allerdings inzwischen auch beim Design solcher hochgradig komplexen Systeme Unterstützung leisten, erläutert Hie. Das sei auch notwendig: An viele wichtige biologische Funktionen komme man nur heran, wenn man ganze Genome am Computer entwerfen könne.
Training für die Attacke auf E. coli
Für seine Studie nutzte das Team die KI-Modelle Evo 1 und Evo 2, die DNA-, RNA- und Proteinsequenzen analysieren und generieren können. Als Designvorlage wählte das Team die Phage ΦX174, ein kleines, seit Jahrzehnten erforschtes DNA-Virus mit 5386 Nukleotiden, verteilt auf elf Gene. Es enthält alle Elemente, die für Infektion und Replikation nötig sind.
Die Evo-Modelle waren bereits mit mehr als zwei Millionen Phagengenomen trainiert worden. Anschließend entwickelte sie das Team gezielt weiter, bis sie Varianten von ΦX174 erzeugten, die E.-coli-Stämme infizieren – speziell solche, die resistent gegenüber Antibiotika sind.
Aus Tausenden generierter Sequenzen filterten die Forschenden 302 vielversprechende Kandidaten heraus. Die meisten ähnelten ΦX174 noch stark, einige enthielten jedoch völlig neue Gensequenzen. Im Labor wurde die KI-designte DNA künstlich hergestellt und in Wirtsbakterien injiziert. Diese produzierten dann die neuen Viren, die von den Wissenschaftlern anschließend getestet wurden.
Von den 302 Kandidaten konnten 16 tatsächlich E. coli infizieren. In Kombination gelang es mehreren, gleich drei Bakterienstämme anzugreifen – darunter solche, die vom natürlichen ΦX174 nicht befallen werden. »Das war ein überraschendes und sehr aufregendes Ergebnis«, sagt King. »Es zeigt, dass die Methode therapeutisch nützlich sein könnte.«
Chancen und Risiken
»Die Studie demonstriert eindrucksvoll, was heute schon möglich ist, und ebnet den Weg für noch ambitioniertere Anwendungen«, sagt Peter Koo vom Cold Spring Harbor Laboratory in New York, der an der Studie nicht beteiligt war. Zwar reichten die Fähigkeiten des Evo-Modells noch nicht aus, um funktionsfähige Viren ohne menschliches Zutun hervorzubringen. Doch im Zusammenspiel aller Schritte sei es ein Ansatz, mit dem sich tatsächlich vollständige Genome erzeugen lassen könnten.
Gleichzeitig bleiben Sicherheitsfragen. Kritiker warnen, dass künstlich generierte Viren auch Menschen gefährden könnten. Kerstin Göpfrich, Biophysikerin an der Universität Heidelberg, sieht das allerdings weniger als spezielles Problem der KI an. »In der Forschung stellt sich immer wieder dieses Dual-Use-Dilemma. Jeder Fortschritt kann zum Guten wie zum Schlechten genutzt werden.«
Zur Erhöhung der Sicherheit hat das Autorenteam alle Viren vom Training ausgeschlossen, die Eukaryoten – also auch den Menschen – befallen. Die eingesetzten Systeme, der Phage ΦX174 und harmlose E.-coli-Stämme, gelten als nicht pathogen und sind seit Langem bewährte Modelle in der Molekularbiologie.
Langfristig hoffen die Forschenden, dass ihre Methode genutzt werden kann, um mit KI-Hilfe sichere Viren zu entwickeln, mit denen sich Krankheiten behandeln lassen oder die helfen, der wachsenden Antibiotikaresistenz zu begegnen. »Ich bin sicher, dass sich auf diesem Gebiet einiges tun wird – das wird sicher extrem spannend«, sagt Göpfrich.
Wenn Sie inhaltliche Anmerkungen zu diesem Artikel haben, können Sie die Redaktion per E-Mail informieren. Wir lesen Ihre Zuschrift, bitten jedoch um Verständnis, dass wir nicht jede beantworten können.